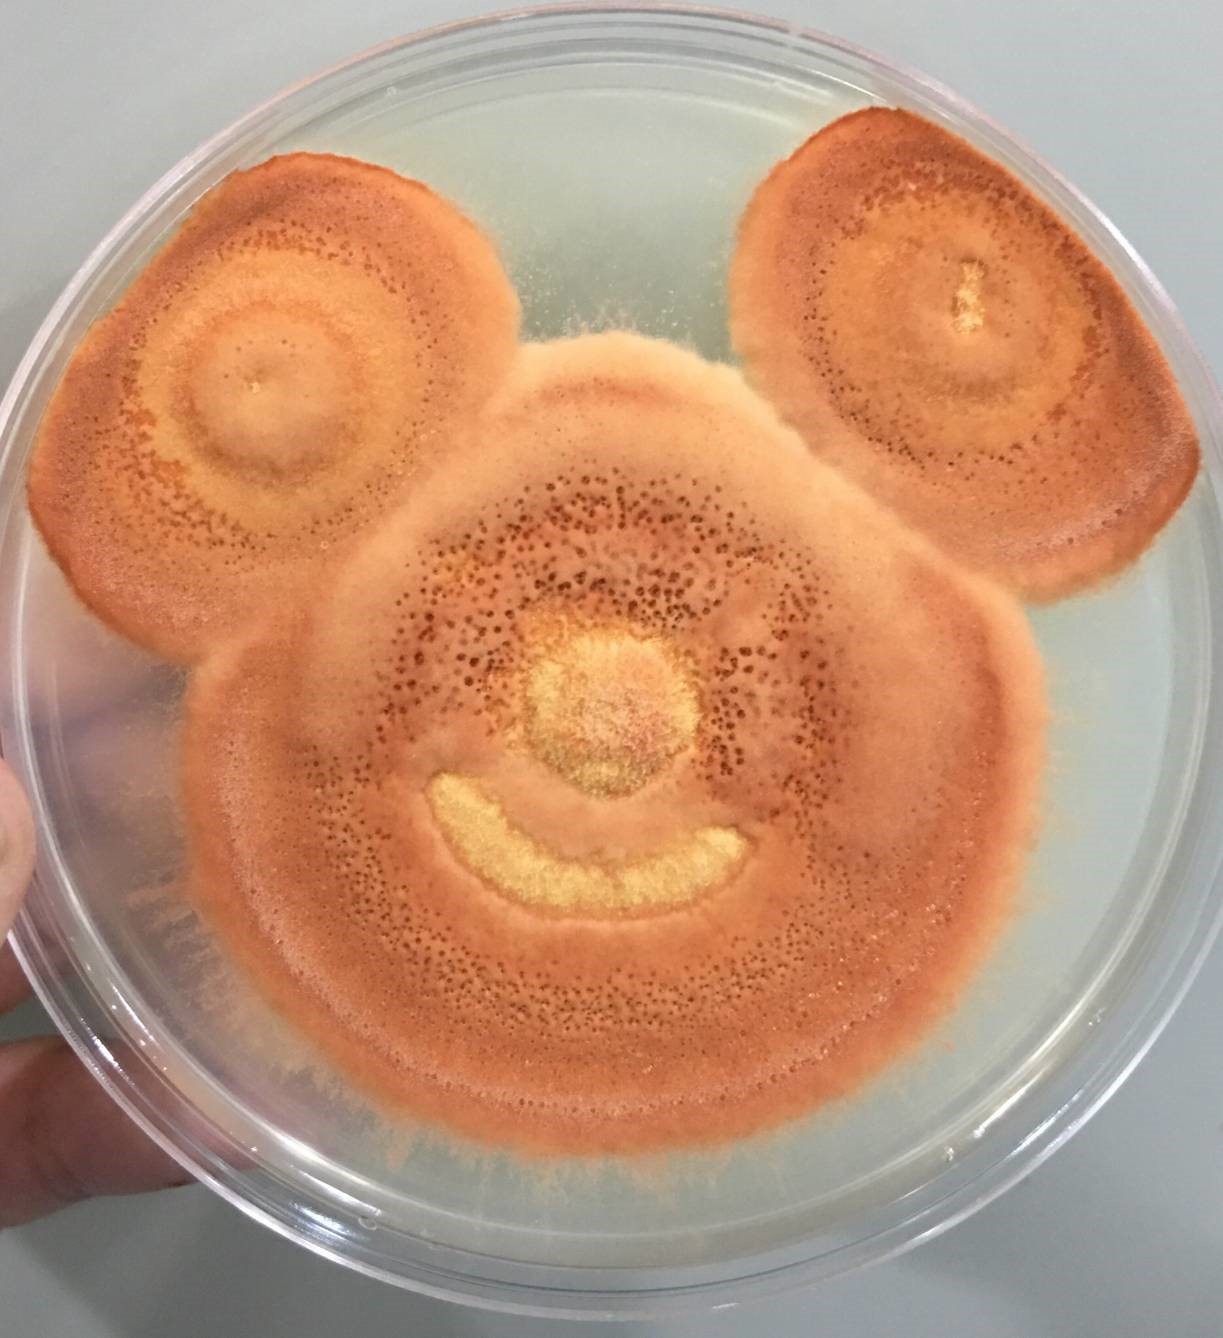
biomass esg OMO antrodia 植化素 皿培 皿培研究所 牛樟芝 子實體 三萜類 樟芝酸 迪士尼 米奇 文創

生醫愛文創
李奧納多·達文西,是義大利文藝復興、整個歐洲文藝復興時期最完美的博學者代表,為多才多藝的畫家、雕塑家、發明家、哲學家、醫學家、生物學家、地理學家、工程師,在科學探索與藝術實踐之間無違和、或互斥,達文西手稿的筆記與繪畫是「藝術+科學」的研究紀錄。
本網站希望拋磚引玉、追尋博學者道路,除了數據化的科學計量外,更細膩觀察、捕捉實驗過程的有趣發現,記錄產品原型的開發,以「生醫+文創」進行資料視覺化(data visualization),用圖像、影像方式呈現。
常看迪士尼米奇老鼠的牛樟芝

牛樟芝普普風海報設計 Pop Art Style Posters

牛樟芝生醫文創長輩圖-農曆新年 Lunar New Year

牛樟芝生醫文創長輩圖-中秋節 Mid-Autumn Festival

牛樟芝生醫文創長輩圖-父親節 Father’s Day

牛樟芝生醫文創長輩圖-母親節 Mother’s Day

牛樟芝生醫文創長輩圖-端午節 Dragon Boat Festival